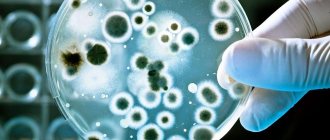

Предупредить заболевания ребенка можно
Наследственность играет огромную роль в формировании человека. Все мы заимствовали какие четы внешности, характера и особенности здоровья от своих родителей, бабушек и дедушек из разных поколений.
Генетика – наука, которая занимается исследованием механизмов заболеваний, передающихся по наследству. В настоящее время, беременным женщинами рекомендуется пройти обследование у генетика, чтобы исключить патологии или же своевременно выявить. Как же происходит эта процедура и так ли она важна?
Гены и успешность
Можно спуститься в исследованиях на уровень ДНК. Человеческая ДНК почти вся одинаковая — это то, что делает нас людьми, но в популяции можно зарегистрировать по всему геному некоторые различия в составляющих его элементах и посмотреть, как они коррелируют с различиями в образовательных достижениях.
Еще одна группа исследователей во главе с Корнелиусом Ритвельдом провела исследование на 120 000 индивидах — это очень крупная выборка. Они взяли широкий показатель: сколько лет эти люди посвятили образованию. Оказалось, что предсказательная сила различий в ДНК очень мала: корреляции очень слабы, и заметить их можно только на очень больших выборках. Это говорит о том, что различия в образовательных достижениях зависят от совместной работы многих генов. Это очень странно, поскольку известно, что наследуемость семейных черт составляет около 40%, но зарегистрированные корреляции между различиями в ДНК и образовательными достижениями объясняли только 2% дисперсии в образовательных достижениях. Таким образом, если используется метод исследования семейного сходства, оказывается, что гены задают 40% различий, но если измерять гены напрямую, то ничего похожего не наблюдается.
Интересно, что в Новой Зеландии было проведено еще одно исследование, в котором эти ДНК-маркеры применили к другой выборке — на этот раз к группе взрослых людей, которые уже прожили долгую жизнь. Можно было узнать, что с ними происходило в разные моменты жизни. Оказалось, что участки ДНК, которые предсказывают школьные успехи, также предсказывали никак не связанные с образованием показатели, такие как заработок. Были выявлены интересные корреляции: если ДНК предсказывает, что вы будете, например, успешны в образовании, у вас наверняка будет обеспеченная семья.
И третье, что показало это исследование: хотя ДНК предсказывает, что человек будет успешен при получении образования, это не значит, что у него будет счастливая жизнь. Некоторые из тех, у кого были хорошие образовательные способности, не были счастливее или здоровее остальных. Таким образом, этот комплекс генов оказывает общие эффекты на успехи в освоении разных дисциплин. Но, по-видимому, на счастье и на здоровье они не влияют. Таким образом, в этой области еще остались загадки.
Важность генетической консультации при беременности
Популярность эта процедура приобрела в прошлом веке потому, что наука далеко шагнула и появилась возможность диагностировать заболевания, которые передаются по наследству или же возникают из-за ряда других причин, внутриутробно. Каждых родителей волнует здоровье будущего малыша, поэтому обследование актуально, особенно для пар, где высокий риск патологий. Например, если кто-то из партнёров страдает эпилепсией, гемофилией, астмой, сахарным диабетом и другими тяжелыми болезнями.
При планировании беременности, многие пары приходят на консультацию к генетику заранее, чтобы исключить проблемы, но сделать процедуру не поздно и при состоявшемся зачатии.
Консультация со специалистом-генетиком необходима, чтобы убедиться в здоровье малыша, выявить предрасположенность к тем или иным заболеваниям, или же определить уже существующие мутации и патологии.
Данная процедура находится в свободном доступе и родители в любое время могут записаться на приём и пройти обследование. В ходе беседы обязательно рассказывайте о причинах, возможных подозрениях и сдать соответствующие анализы.
Женщины из группы риска
Как и при любых других случаях, существует группа риска, куда входят роженицы:
- В возрасте от 35 лет. У пациентов высокий уровень опасности появления ребёнка с отклонениями.
- При наличии родственников, которые страдают наследственными заболеваниями.
- При анамнезе с несколькими выкидышами, рождением мертвых детей, бесплодии.
- Если пара является кровными родственниками.
- Контакт женщины с агрессивными ядовитыми веществами, радиационное облучение или химическое воздействие.
- Наличие детей с хромосомными патологиями.
- Женщины с заболеваниями эндокринной системы.
- Многоплодная беременность.
Дополнительные причины для проведения
Дополнительными факторами для назначения процедуры – негативные анализы, показатели перинатального скрининга или же собственное желание беременной. Перенесённые заболевания в период вынашивания малыша и приём медикаментов, которые могут отрицательно сказаться на здоровье плода.
Какие генетические анализы перед ЭКО нужно сдавать ?
Если семейной паре назначена генетика при ЭКО , анализы сдаются в следующих целях:>
- проведение HLA-типирования;
- изучение кариотипов мужа и жены;
- тестирование на предмет наличия распространённых генетических патологий (фенилкетонурии, муковисцидоза, галактоземии, амиотрофии).
В сфере репродуктологии сейчас разработано несколько эффективных методик ПГД, помогающих качественно исследовать генетические анализы перед ЭКО.
- ПЦР. Суть полимеразной цепной реакции заключается в определении специфических дубликатов ДНК. Чтобы вычленить один фрагмент из двойной цепи ДНК для дальнейшего исследования, генетики проводят процедуру денатурации. Далее специалисты подмешивают к взятому биоматериалу особые ферменты, которые постепенно увеличивают его объём в 2 раза. Благодаря этому можно легко обнаружить аномальные участки в нуклеотиде. Методика ПЦР даёт хороший эффект при выявлении моногенных патологий. Она рекомендована для исследования биоматериалов супругов, которые являются носителями «плохих» генов или имеют клинические признаки наследственных заболеваний.
- FISH. Помогает диагностировать изменения в хромосомах, которые носят структурный либо числовой характер (транслокации, анеуплоидии). Чтобы идентифицировать патологические и здоровые хромосомы при помощи данного метода, специалисты проводят ряд лабораторных манипуляций с клетками. После взятия биопсии исследуемые клетки закрепляются на предметном стекле, подвергаются нагреву и охлаждению. От температурного воздействия оболочка клетки разрывается, из неё выходит цитоплазма. Лаборант помечает участки ДНК флуоресцентным красителем, а затем, при помощи специального микроскопа, считает количество аномальных хромосом.
- Инновационный метод NGS. Диагностика биоматериала выполняется в криоцикле по методике NGS. Схема позволяет специалистам тщательно изучить все пары хромосом (которых насчитывается 23). Метод отличается наивысшей точностью (99,9%). Одновременно с исследованием хромосомных пар проводится изучение их патологий, мутаций, моногенных болезней. Процесс диагностики хорошо автоматизирован, поэтому дополнительные неточности исключены. После анализа NGS необходимость в биопсии бластомеров отпадает.
Что делает врач генетик при беременности
Процедуру проводят с помощью двух способов:
- Неинвазивный – женщина проходит УЗИ, сдаёт биохимический анализ крови на маркеры.
- Инвазивный – предполагает проникновение в полость матки, откуда берутся материалы для обследования, чтобы выявить кариотип плода. Применяется биопсия хориона, амниоцентез, плацентоцентез, кордоцентез. Происходит забор клеток из плаценты, пуповины, околоплодных вод и крови плода. Данные процедуры разрешены только по строгому предписанию доктора и в стационарных условиях, по окончании манипуляций женщине необходимо некоторое время, чтобы прийти в порядок.
Различают три уровня угрозы для ребёнка:
- Вероятность 10% – данный показатель означает, что опасности для здоровья малыша нет.
- Значение от 10% до 20% – вероятность появления здорового ребёнка и с заболеваниями одинакова. Такой результат требует дальнейших обследований, чтобы выявить точный риск.
- Выше 20% – возможность зачатия малыша без патологий отсутствует, рекомендована процедура ЭКО для вынашивания здорового дитя.
Особое внимание у женщин со сложной и многоплодной беременностью. Например, пациенты с сахарным диабетом обязательно сдают анализ на содержание глюкозы в крови (глюкозотолерантнтный тест), белка и печеночных ферментов.
Не нужно игнорировать процедуру генетического исследования даже если нет никаких причин для волнения и недомоганий во время вынашивания ребёнка.
Главная опасность хромосомных отклонений в том, что в большинстве они абсолютно не проявляются и отсутствуют симптомы. Генетическое заболевание может проявиться даже через несколько поколений, поэтому важно проконсультироваться и сдать анализы, чтобы удостовериться, что у малыша нет никаких проблем.
Несмотря на высокий уровень медицины, существует процент погрешности. Бывают случаи, когда специалисты выявляли мутации с которыми ребёнок не жизнеспособен, но у женщины появлялся здоровый малыш. Однако, такой исход имеет малую долю вероятности.
Генеалогический метод диагностики наследственных заболеваний
Это один из старейших среди существующих методов диагностики: например, в Московском НИИ педиатрии и детской хирургии соответствующая служба работает с 1970 года [2] . А основные его принципы были сформулированы еще в XIX веке [3] .
Суть генеалогического метода состоит в составлении генетических карт, которые позволяют выяснить, является ли конкретное заболевание наследственным, как именно оно наследуется и какова вероятность его проявления у пациента. Также метод применяется для прогнозирования рождения детей с различными заболеваниями.
Основной инструмент исследования в данном случае — подробный опрос пациента и получение максимально полной информации о его родственниках. Если пациентом является ребенок, то генетик собирает максимально полную информацию у матери — о протекании беременности, родах, о первых годах жизни. Если к врачу обращается взрослый человек, то сбор информации напоминает сбор анамнеза при визите к терапевту, но более детальный. По возможности врач лично опрашивает и родственников пациента.
Данный метод предполагает большую аналитическую работу, основанную на полученных данных. Таким образом, генеалогический метод — это своеобразное связующее звено между теоретической генетикой и практической медициной. Если исследование проводится с целью планирования беременности, врач указывает вероятность рождения у конкретной пары детей с теми или иными генетическими нарушениями. При обследовании семьи также может быть выявлен круг лиц, у которых высока вероятность проявления наследственных заболеваний. Этим людям рекомендуется провести более точную лабораторную диагностику.
Стоимость консультации врача-генетика в Москве начинается от 2000 рублей [4] .
Молекулярно-генетические методы исследования наследственных болезней
Эти методы выявления наследственных заболеваний позволяют фактически заглянуть внутрь ДНК, на которой записана наследственная информация. Они разнообразны: FISH (выявление генетических мутаций с помощью специально помеченных фрагментов ДНК-зондов), ПЦР (метод отличается высокой точностью и позволяет выявлять инфекцию в организме, даже если ее присутствие очень ограниченно), CGH (метод используется в онкологической генетике), SKY (метод, при котором используются особые красители, реагирующие на конкретные участки ДНК) и другие.
Область применения молекулярно-генетических методов широка. В частности, при перинатальной диагностике они позволяют обнаружить нарушения у ребенка еще до его рождения. В случае если женщина прибегает к ЭКО, выявить возможные генетические сбои можно еще до имплантации зародыша в матку.
Также проводится анализ на наследственные заболевания у новорожденных.
Еще несколько лет назад будущим мамам предлагалось пройти инвазивную генетическую диагностику, чтобы убедиться в наличии или отсутствии нарушений у плода. Для анализа бралась амниотическая жидкость, и манипуляция несла определенную угрозу для нормального протекания беременности. Сегодня существует неинвазивная диагностика (NIFTY), которая позволяет выявлять ДНК ребенка при анализе крови матери на наследственные заболевания [5] . С высокой степенью точности (более 98% [6] ) она помогает диагностировать такие опасные патологии, как синдромы Дауна, Эдвардса, Патау.
Молекулярно-генетические методы применяются не только для перинатальной диагностики, но и для выявления других заболеваний: ВИЧ, туберкулез, энцефалит, гепатит и другие. Материал для изучения получается из разных тканей: это может быть кровь, слюна, мокрота. Генетические исследования не только позволяют провести точную диагностику, но и подобрать оптимальное лечение. В частности, они помогают определить чувствительность возбудителя заболевания к препаратам и выбрать тот, который даст наиболее выраженный эффект при лечении.
Стоимость диагностики зависит от объема исследования и может начинаться от 1000 рублей (ПЦР) [7] .
Биохимические методы
Выявить многие наследственные болезни обмена веществ (НБО), такие как фенилкетонурия, болезни пуринового обмена, гликогеновую болезнь, позволяют биохимические методы. При НБО в организме накапливаются продукты несовершенного метаболизма, и их обнаружение помогает установить диагноз.
Как правило, предположить наличие НБО можно в самом раннем возрасте: у детей отмечают задержку развития, различные нарушения пищеварения, пигментацию кожи, аллергии и т.д. Для анализа берутся кровь или моча.
Обычно биохимическая диагностика проводится в два этапа. Сначала проводят общий анализ, например, у всех новорожденных на наличие фенилкетонурии. Общие обследования также могут проходить все воспитанники специальных учебных заведений. Детей с отклонениями биохимических показателей направляют на более детальное и сложное обследование, которое проводят в генетических лабораториях.
Стоимость биохимического анализа крови по одному параметру в Москве составляет порядка 200 рублей [9] .
Цитогенетический метод
Цитогенетика, наряду с генеалогическим методом, один из самых старых типов диагностики наследственных заболеваний. Еще в XIX веке ученые могли наблюдать хромосомы клеток под микроскопом [10] . С того времени задачи цитогенетики практически не изменились: она изучает состояние хромосом и выявляет патологии в них. Метод входит в перечень обследований для беременных женщин, утвержденный Министерством здравоохранения Российской Федерации [11] . Цитогенетическое обследование проходят будущие мамы в возрасте старше 35 лет, носители семейных заболеваний. Оно проводится, если у плода обнаружены настораживающие врача отклонения.
Для исследования берут кровь, клетки которой проходят специальную подготовку. В обычном состоянии хромосомы как бы скручены в плотную спираль, поэтому оценить наличие в них повреждений нельзя. Для изучения клетки искусственно вводят в состояние деления, и когда нить хромосомы раскручивается, из нее делают препарат.
Цитогенетические методы применяется в ранней диагностике патологий детей, а также помогают выявлять причины нарушения репродуктивной функции, особенно неясного генеза, у мужчин и женщин.
Стоимость цитогенетического исследования кариотипа в Москве составляет порядка 6700 рублей [12] .
Читай также
Профилактика дисплазии тазобедренных суставов: как предотвратить и предупредить развитие болезни правильно?
Дерматоглифика
С этим методом хорошо знакомы все: дактилоскопия, или изучение рисунка кожи пальцев, относится к дерматоглифике. Существуют и другие методы — пальмоскопия (изучение рисунка на ладонях) и плантоскопия (изучение рисунка кожи на подошвах). Особенности кожного рисунка изучал чешский ученый Ян Пуркинье, который воздал фундаментальную классификацию пальцевых узоров [13] . Его последователи выяснили, что некоторые изменения рисунка кожи по сравнению с нормой свидетельствует о генетических заболеваниях [14] . Например, по расположению гребней и борозд на коже можно предположить такие патологии, как синдром Клайнфельтера, синдром кошачьего крика, синдром Тернера и даже мультифакторные заболевания — диабет, рак и другие.
Дерматоглифический анализ является частью осмотра пациента в генетической клинике.
Метод выявления гетерозиготного носительства
Ряд наследственных заболеваний определяется повреждением только одного гена (так называемые моногенные заболевания). К ним относятся некоторые эндокринные нарушения, иммунные расстройства, болезни центральной нервной системы и т.д. Так как ребенок получает генетическую информацию от двух родителей, может сложиться ситуация, когда и мать, и отец здоровы, но у них рождается больной ребенок, так как оба родителя передали ему мутированные гены. Чтобы установить, не является ли один из родителей (или оба) носителями наследственных заболеваний, и какова вероятность проявления их у ребенка, проводится анализ на гетерозиготное носительство.
Некоторые болезни, в том числе синдром Марфана или несовершенный остеогенез, передаются детям, даже если только один родитель является их носителем. В этом случае во время планирования беременности нужно обязательно пройти консультацию у генетика: он назовет вероятность рождения ребенка с генетической патологией.
Заболевания могут быть сцеплены с полом, то есть ген, кодирующий их, содержится только в половой хромосоме (гемофилия, мышечная дистрофия). По этим патологиям также рассчитывается риск проявления их у детей. Гетерозиготное носительство выявляется в ходе различных видов генетической диагностики.
Генетическое прогнозирование
Около 90% всех заболеваний человека являются многофакторными [15] . Генетические особенности определяют предрасположенность человека к патологии, а при действии определенных факторов среды заболевание может развиться либо нет. Факторы среды тоже отличаются разнообразием: это может быть и экология, и особенности питания как самого человека, так и его матери во время беременности, и регион проживания, и т.д.
Предположить, какова вероятность заболевания, можно в ходе медико-генетического консультирования и по итогам генетических анализов. Сегодня их делают самой разной степени сложности и по многим параметрам. Например, можно изучить генетическое здоровье супружеской пары, установить вероятность развития рака при курении, определить, насколько высока необходимость защищать кожу от действия УФ-лучей.
Пренатальная диагностика наследственных заболеваний
Ввиду актуальности проблемы данное направление генетической диагностики заслуживает особого внимания. Речь идет не об одном методе исследования, а о совокупности. Обследование проводят в период внутриутробного развития ребенка, чтобы выявить врожденные нарушения. По оценке ВОЗ, именно они становятся причиной примерно 7% случаев неонатальной смерти [16] . Раннее, еще до рождения, выявление этих нарушений позволяет быстро начать необходимое лечение, а в некоторых случаях даже провести внутриутробную операцию.
Показаниями к проведению пренатальной диагностики являются:
- генетические заболевания, встречавшиеся у членов семьи;
- возраст женщины (старше 35–37 лет);
- выявленное генетическое носительство патологии, сцепленной с полом;
- гетерозиготность родителей по ряду генетических патологий;
- неудачные беременности в анамнезе, прерывавшиеся по неясным причинам.
Методы дородовой диагностики очень разнообразны: УЗИ плода, генетический анализ амниотической жидкости или пуповинной крови, изучение сыворотки крови матери, биопсия ворсин хориона и другие. Целесообразность применения каждого из этих методов определяет врач.
Благодаря достижениям медицины сегодня мы имеем возможность проходить подробную диагностику в области развития наследственных заболеваний. Будущие родители могут узнать о вероятности рождения ребенка с той или иной патологией. Наличие этой информации помогает принять правильное решение, вовремя начать лечение, скорректировать образ жизни, заняться профилактикой развития генетических болезней.
На каком сроке проводится консультация врача генетика при беременности
Первое обследование обычно назначают на конец первого триместра – 10-12 неделя. Если результаты отличные, не требует дополнительных анализов, то следующая консультация проходит после 20 недели.
Затем контрольное исследование делают в период 30-32 недели беременности. При сложной беременности и возможных угрозах, приём генетика может быть проведен в другие сроки.
После рождения ребёнка, происходит забор крови из пальцев на ногах новорождённого на наличие патологий.
Генетическое обследование выявляет проблемы с 85% вероятности.
Нынешняя экология и ритм жизни людей не очень благоприятно сказывается на здоровье. Поэтому, чтобы зачать и родить здорового ребёнка без патологий, настоятельно рекомендовано специалистами посетить перед планированием врача генетика.
Как проходит прием у генетика
На прием к врачу будущим родителям стоит сходить вместе, предварительно подготовившись и захватив с собой медицинские карты и данные анализов. Ведь специалист, прежде всего, должен будет получить информацию обо всех тяжелых и наследственных недугах в семье. После этого доктор назначит дополнительные исследования, по их результатам сделает выводы и прогнозы.
Какие вопросы задает генетик беременной
Прежде всего, врач поинтересуется, есть ли какие-нибудь физические отклонения у будущих родителей и их близких родственников. Какие тяжелые заболевания они перенесли, чем болели их родители и бабушки-дедушки. Есть ли в семье наследственные заболевания или генетические аномалии. Возможно, кто-то из будущих родителей уже имеет ребенка с патологиями.
В случае, если изменения в развитии старшего ребенка произошли в связи с обстоятельствами внутриутробного периода (перенесенная инфекция, травмы, и так далее), то новая беременность может пройти без осложнений и развития патологий.